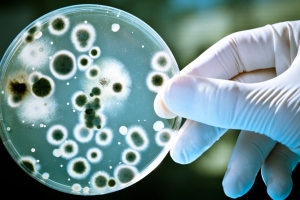
S-a descoperit „veriga lipsă” dintre cele două principale forme de viaţă de pe Terra

Căutam colaboratori!
Și tu poți fi reporter pe 101știri.ro. Trimite-ne ce ai auzit sau văzut interesant, foto, text sau video ori scrie un articol, două, zece și poți să fii reporter pentru o zi. Sau de ce nu... chiar mai mult! Aviz studenților la Jurnalism și tuturor celor care au ceva de spus. Contactați-ne pe office@101stiri.ro